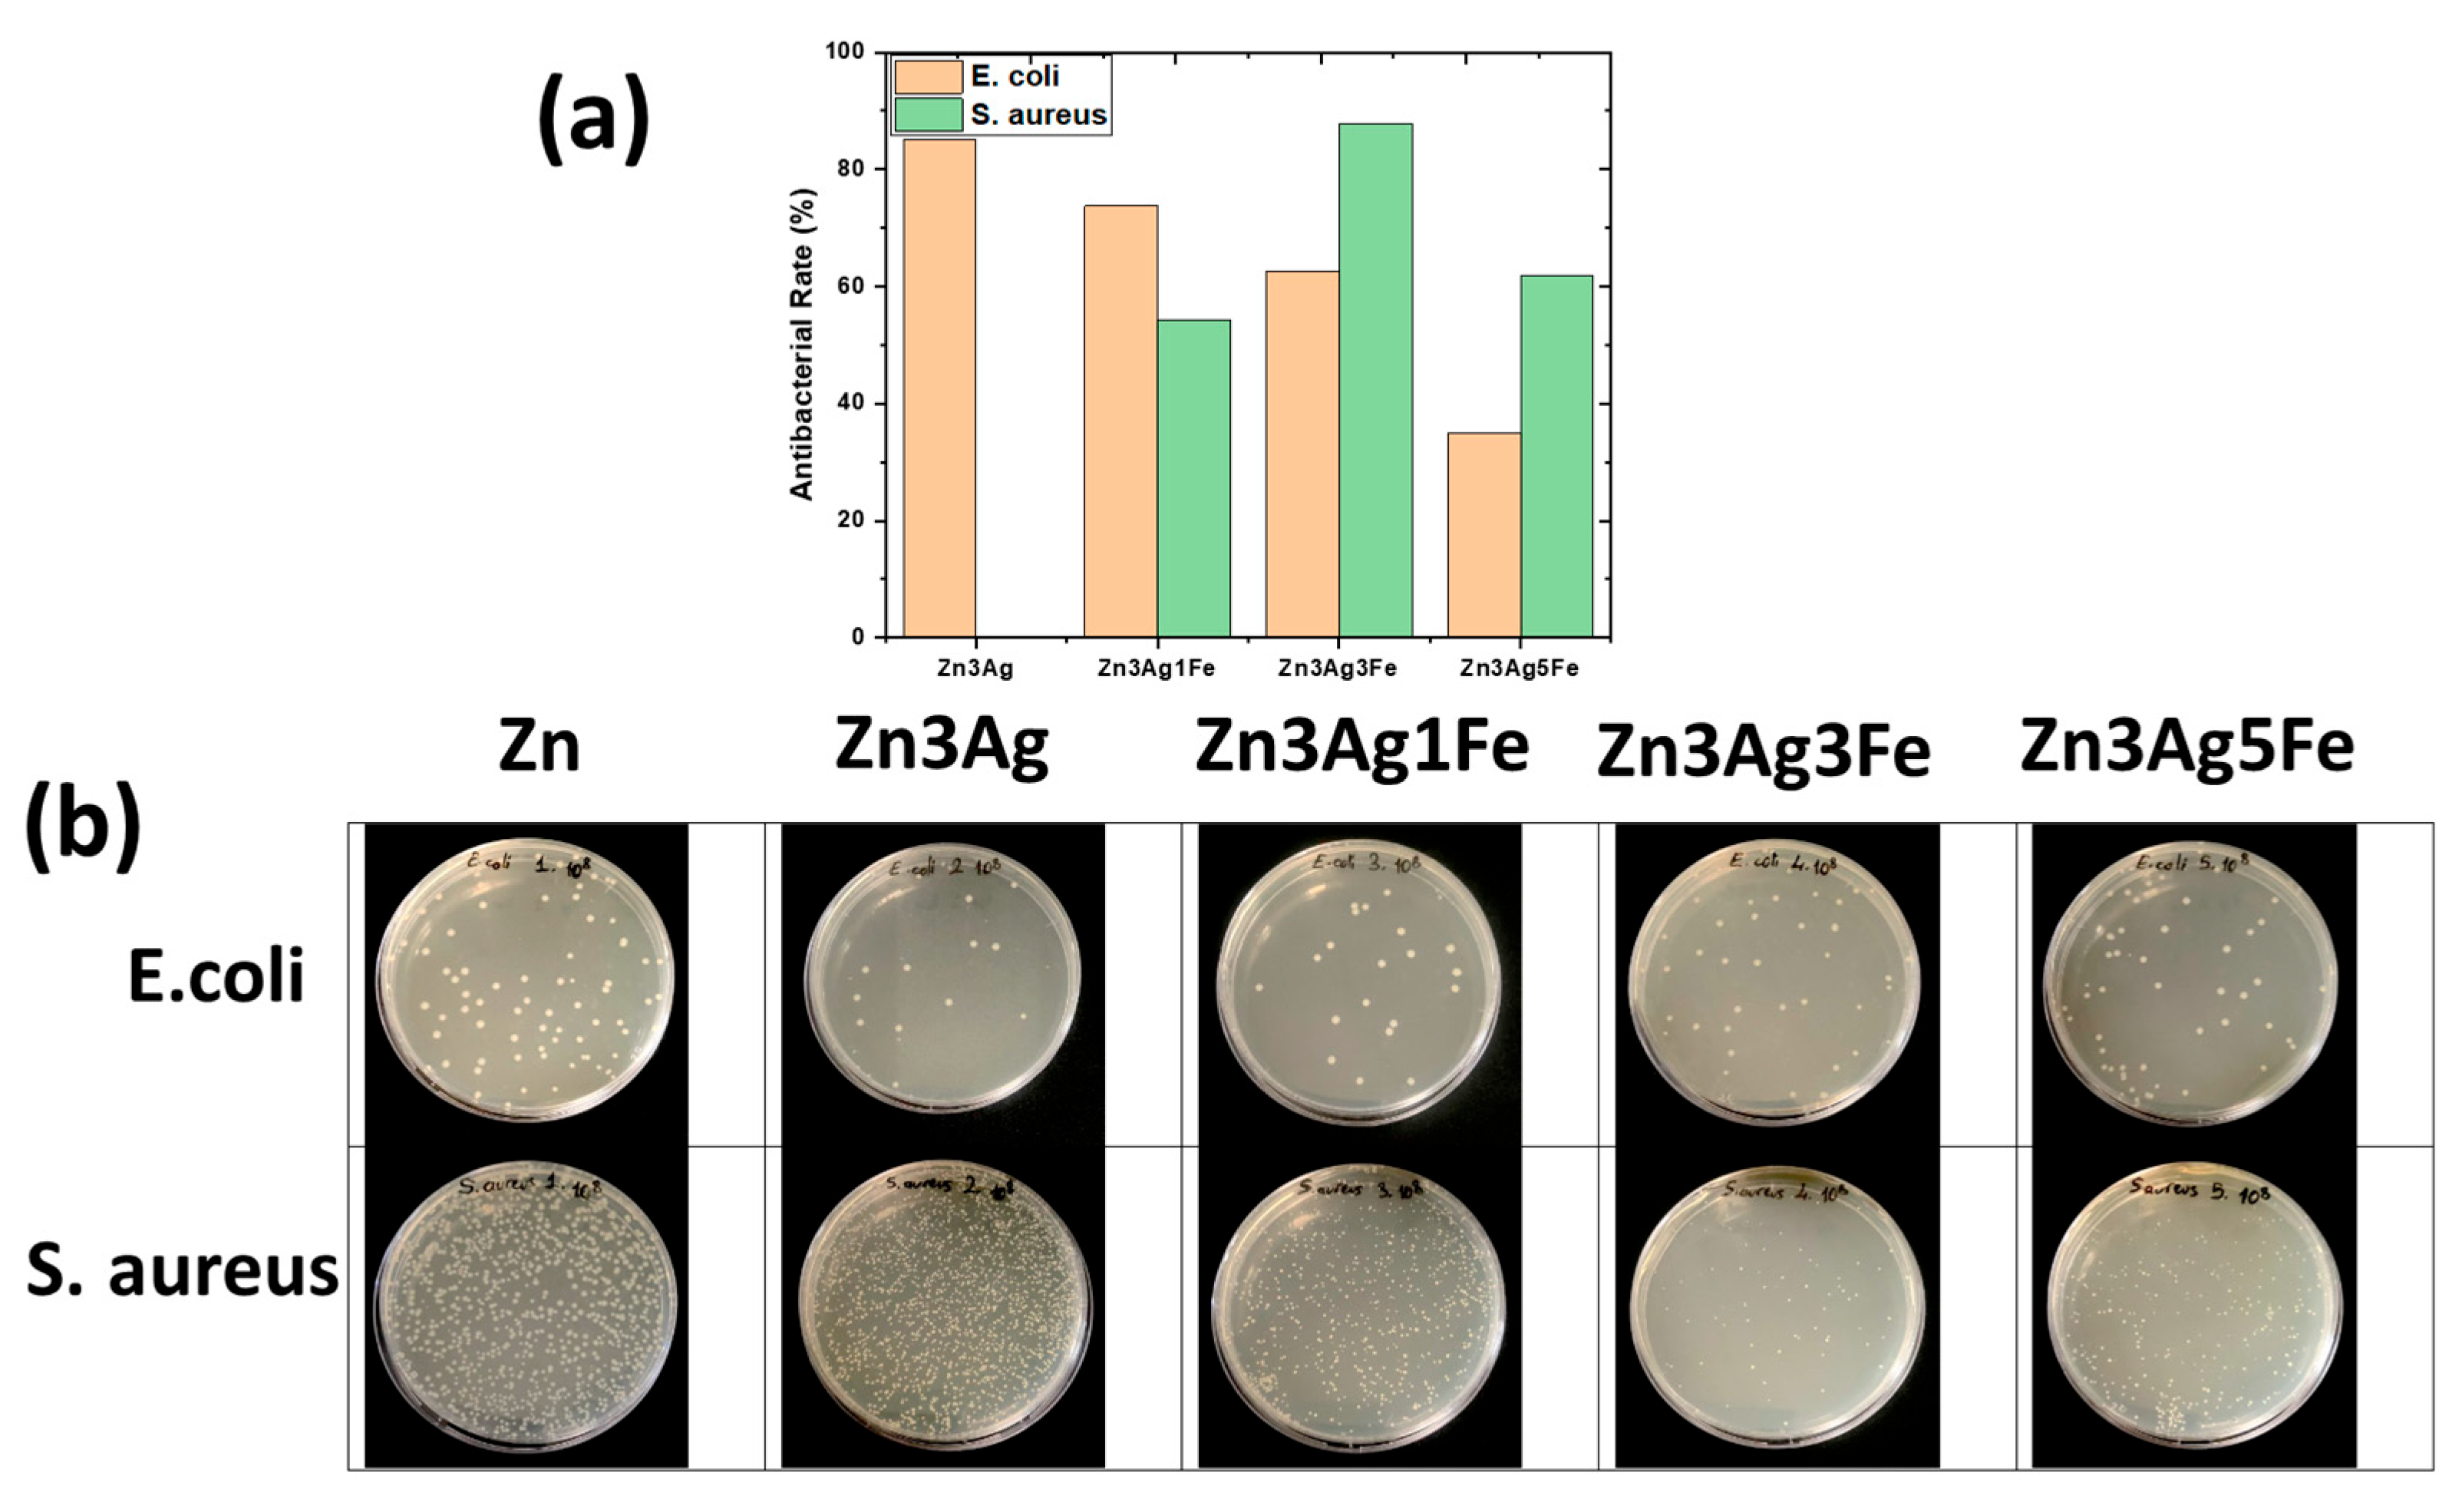
Jfb 16 00435 g008

Effect of Iron on the Microstructure, Mechanical Properties, Corrosion Behavior, and Biocompatibility of Mechanically Alloyed Zn-3Ag Biodegradable Alloys
Abstract
1. Introduction
2. Materials and Methods
2.1. Alloy Preparation and Consolidation
2.2. Microstructural and Phase Characterization
2.3. Physical and Mechanical Properties
2.4. Electrochemical Tests
2.5. In Vitro Biocompatibility Assessment
2.5.1. Cytotoxicity Assay Procedure
2.5.2. Live/Dead Staining
2.6. Antibacterial Activity Test
2.7. Statistical Analysis
3. Results and Discussion
3.1. Structural and Phase Evolution During Mechanical Alloying
3.2. Morphological Evolution During Mechanical Alloying
3.3. Density and Mechanical Properties
3.4. Electrochemical Properties
3.5. Cytotoxicity Assay
3.6. Antibacterial Activity
4. Conclusions
- Zn-Ag-Fe alloys produced through mechanical alloying exhibited intermetallic phases of AgZn3 and Fe3Zn10, as verified by XRD analysis. SEM/EDX examination indicated that the dimensions and proportion of the intermetallic phase expanded with the increase in alloying content.
- Prior to sintering, the alloying constituents rendered the material less compressible and more porous. Following sintering, the porosity significantly decreased. The Zn-3Ag-5Fe alloy exhibited 15.35% porosity, whereas the pure Zn demonstrated 11.62% porosity.
- The hardness increased with the rising concentration of alloying elements due to the formation of hard intermetallic phases. Zn-3Ag-5Fe attained a hardness of 132.8 HV. The Archard equation demonstrated that wear resistance improved with an increase in alloying content.
- The addition of Ag and Fe increased the nobility (OCP: −986.7 mV → −774.6 mV). The corrosion rate increased from 0.51 to 2.81 mm/year due to the material’s increased porosity and higher intermetallic content. The EIS results indicated that pure Zn exhibited the highest resistivity.
- All samples demonstrated toxicity at 100% extract concentration, although cell viability surpassed 85% at 12.5% extract concentration. The addition of Fe diminished cell viability due to an elevated corrosion rate. The addition of Ag did not have a substantial cytotoxic effect.
- The addition of Ag enhanced its efficacy against E. coli, but not against S. aureus. Increased Fe enhanced the antibacterial action against S. aureus by facilitating more degradation.
Supplementary Materials
Author Contributions
Funding
Institutional Review Board Statement
Informed Consent Statement
Data Availability Statement
Acknowledgments
Conflicts of Interest
Abbreviations
| MA | Mechanical alloying |
| SEM | Scanning electron microscopy |
| EDX | Energy-dispersive X-ray spectroscopy |
| XRD | X-ray diffraction |
| FWHM | Width at half maximum |
| MRI | Magnetic resonance imaging |
| HV | Vickers microhardness |
| HBSS | Hank’s balanced salt solution |
| SCE | Saturated calomel electrode |
| OCP | Open circuit potential |
| α-MEM | alpha-minimum essential medium |
| FBS | Fetal bovine serum |
| CCK-8 | Cell counting kit-8 |
| OD | Optical density |
| PBS | phosphate-buffer solution |
| 7-AAD | 7-aminoactinomycin D |
| CFU | Colony-forming unit |
| ANOVA | Analysis of variance |
| P | Porosity |
| EIS | Electrochemical impedance spectroscopy |
| E_corr | Corrosion potential |
| i_corr | Current density |
| Rs | Solution resistance |
| Ro | Corrosion product resistance |
| Rm | Charge transfer resistance |
| Qo | Capacitance of the corrosion products |
| Qm | Capacitance between the zinc alloy and the solution |
| LC50 | Llethal concentration |
References
- Makena, I.M.; Shongwe, M.B. Effects of Porosity on the Corrosion Behaviour of PM-Fabricated Titanium Foams for Biomedical Applications. Int. J. Electrochem. Sci. 2024, 19, 100495. [Google Scholar] [CrossRef]
- Yng, Y.; Chan, K.F.; Abd Samad, M.I.; Ramlee, M.H.; Yaakob, Y.; Tanemura, M.; Mohd Yusop, M.Z. Powder Metallurgy of Zn–Mn/CNF Biodegradable Composites: Role of Ball Milling and Sintering on Material Performance. Mater. Chem. Phys. 2025, 332, 130314. [Google Scholar] [CrossRef]
- Zheng, Y.F.; Gu, X.N.; Witte, F. Biodegradable Metals. Mater. Sci. Eng. R Rep. 2014, 77, 1–34. [Google Scholar] [CrossRef]
- Yuan, K.; Deng, C.; Tan, L.; Wang, X.; Yan, W.; Dai, X.; Du, R.; Zheng, Y.; Zhang, H.; Wang, G. Structural and Temporal Dynamics Analysis of Zinc-Based Biomaterials: History, Research Hotspots and Emerging Trends. Bioact. Mater. 2024, 35, 306–329. [Google Scholar] [CrossRef]
- Katarivas Levy, G.; Goldman, J.; Aghion, E. The Prospects of Zinc as a Structural Material for Biodegradable Implants—A Review Paper. Metals 2017, 7, 402. [Google Scholar] [CrossRef]
- Cimpoesu, N.; Paleu, V.; Panaghie, C.; Roman, A.-M.; Cazac, A.M.; Cioca, L.-I.; Bejinariu, C.; Lupescu, S.C.; Axinte, M.; Popa, M.; et al. Mechanical Properties and Wear Resistance of Biodegradable ZnMgY Alloy. Metals 2024, 14, 836. [Google Scholar] [CrossRef]
- Qin, Y.; Wen, P.; Voshage, M.; Chen, Y.; Schückler, P.G.; Jauer, L.; Xia, D.; Guo, H.; Zheng, Y.; Schleifenbaum, J.H. Additive Manufacturing of Biodegradable Zn-XWE43 Porous Scaffolds: Formation Quality, Microstructure and Mechanical Properties. Mater. Des. 2019, 181, 107937. [Google Scholar] [CrossRef]
- Shuai, C.; Zhao, Y.; Li, C.; Deng, Y.; Zhao, Z.; Gao, C. Supersaturated Solid Solution Enhanced Biodegradable Zn-Mn Alloys Prepared by Mechanical Alloying and Selective Laser Melting. J. Alloys Compd. 2023, 943, 169145. [Google Scholar] [CrossRef]
- Yang, H.; Jia, B.; Zhang, Z.; Qu, X.; Li, G.; Lin, W.; Zhu, D.; Dai, K.; Zheng, Y. Alloying Design of Biodegradable Zinc as Promising Bone Implants for Load-Bearing Applications. Nat. Commun. 2020, 11, 401. [Google Scholar] [CrossRef]
- Li, H.F.; Xie, X.H.; Zheng, Y.F.; Cong, Y.; Zhou, F.Y.; Qiu, K.J.; Wang, X.; Chen, S.H.; Huang, L.; Tian, L.; et al. Development of Biodegradable Zn-1X Binary Alloys with Nutrient Alloying Elements Mg, Ca and Sr. Sci. Rep. 2015, 5, 10719. [Google Scholar] [CrossRef]
- Sun, J.-L.; Feng, Y.; Shi, Z.-Z.; Xue, Z.; Cao, M.; Yao, S.-L.; Li, Z.; Wang, L.-N. Biodegradable Zn-0.5Li Alloy Rib Plate: Processing Procedure Development and in Vitro Performance Evaluation. J. Mater. Sci. Technol. 2023, 141, 245–256. [Google Scholar] [CrossRef]
- Jia, B.; Yang, H.; Han, Y.; Zhang, Z.; Qu, X.; Zhuang, Y.; Wu, Q.; Zheng, Y.; Dai, K. In Vitro and in Vivo Studies of Zn-Mn Biodegradable Metals Designed for Orthopedic Applications. Acta Biomater. 2020, 108, 358–372. [Google Scholar] [CrossRef] [PubMed]
- Du, S.; Shen, Y.; Zheng, Y.; Cheng, Y.; Xu, X.; Chen, D.; Xia, D. Systematic in Vitro and in Vivo Study on Biodegradable Binary Zn-0.2 At% Rare Earth Alloys (Zn-RE: Sc, Y, La–Nd, Sm–Lu). Bioact. Mater. 2023, 24, 507–523. [Google Scholar] [CrossRef]
- Xiao, X.; Liu, E.; Shao, J.; Ge, S. Advances on Biodegradable Zinc-Silver-Based Alloys for Biomedical Applications. J. Appl. Biomater. Funct. Mater. 2021, 19, 1–11. [Google Scholar] [CrossRef]
- Güner, A.T.; Meran, C. Ortopedik implantlarda kullanılan biyomalzemeler TT—Biomaterials used in orthopedic implants. Pamukkale Üniversitesi Mühendislik Bilim. Derg. 2020, 26, 54–67. [Google Scholar] [CrossRef]
- Ramirez–Ledesma, A.L.; Roncagliolo-Barrera, P.; Alvarez–Perez, M.A.; Juarez–Islas, J.A.; Paternoster, C.; Copes, F.; Mantovani, D. Introducing Novel Bioabsorbable Zn–Ag–Mg Alloys Intended for Cardiovascular Applications. Mater. Today Commun. 2023, 35, 105544. [Google Scholar] [CrossRef]
- Shuai, C.; Xue, L.; Gao, C.; Yang, Y.; Peng, S.; Zhang, Y. Selective Laser Melting of Zn–Ag Alloys for Bone Repair: Microstructure, Mechanical Properties and Degradation Behaviour. Virtual Phys. Prototyp. 2018, 13, 146–154. [Google Scholar] [CrossRef]
- Mostaed, E.; Sikora-Jasinska, M.; Ardakani, M.S.; Mostaed, A.; Reaney, I.M.; Goldman, J.; Drelich, J.W. Towards Revealing Key Factors in Mechanical Instability of Bioabsorbable Zn-Based Alloys for Intended Vascular Stenting. Acta Biomater. 2020, 105, 319–335. [Google Scholar] [CrossRef]
- Xue, P.; Ma, M.; Li, Y.; Li, X.; Yuan, J.; Shi, G.; Wang, K.; Zhang, K. Microstructure, Mechanical Properties, and in Vitro Corrosion Behavior of Biodegradable Zn-1Fe-XMg Alloy. Materials 2020, 13, 4835. [Google Scholar] [CrossRef]
- Li, S.; Wang, X.; Ren, J.; Liu, C.; Hu, Y.; Yang, Y. Microstructure, Mechanical Property and Corrosion Behavior of Biomedical Zn-Fe Alloy Prepared by Low-Temperature Sintering. J. Alloys Compd. 2023, 934, 167812. [Google Scholar] [CrossRef]
- Králová, Z.O.; Gorejová, R.; Oriňaková, R.; Petráková, M.; Oriňak, A.; Kupková, M.; Hrubovčáková, M.; Sopčák, T.; Baláž, M.; Maskaľová, I.; et al. Biodegradable Zinc-Iron Alloys: Complex Study of Corrosion Behavior, Mechanical Properties and Hemocompatibility. Prog. Nat. Sci. Mater. Int. 2021, 31, 279–287. [Google Scholar] [CrossRef]
- Tang, L.; Chen, H.; Zhu, X.; Zubair, M.; Sun, T.; Yang, L.; Lu, X.; Song, Z. Enhancing Mechanical and Biodegradation Properties of Zn-0.5Fe Alloys Through Rotary Forging. Materials 2025, 18, 722. [Google Scholar] [CrossRef]
- Zhang, J.; Zhu, X.; Guo, P.; Zhang, Y.; Xu, D.; Pang, Y.; Song, Z.; Yang, L. Effects of Li Addition on the Properties of Biodegradable Zn–Fe–Li Alloy: Microstructure, Mechanical Properties, Corrosion Behavior, and Cytocompatibility. Mater. Today Commun. 2024, 39, 108661. [Google Scholar] [CrossRef]
- Su, Y.; Fu, J.; Lee, W.; Du, S.; Qin, Y.-X.; Zheng, Y.; Wang, Y.; Zhu, D. Improved Mechanical, Degradation, and Biological Performances of Zn–Fe Alloys as Bioresorbable Implants. Bioact. Mater. 2022, 17, 334–343. [Google Scholar] [CrossRef]
- Avior, O.; Ben Ghedalia-Peled, N.; Ron, T.; Vago, R.; Aghion, E. The Effect of Ca on In Vitro Behavior of Biodegradable Zn-Fe Alloy in Simulated Physiological Environments. Metals 2020, 10, 1624. [Google Scholar] [CrossRef]
- Kafri, A.; Ovadia, S.; Yosafovich-Doitch, G.; Aghion, E. In Vivo Performances of Pure Zn and Zn-Fe Alloy as Biodegradable Implants. J. Mater. Sci. Mater. Med. 2018, 29, 94. [Google Scholar] [CrossRef] [PubMed]
- Xu, Y.; Xu, Y.; Zhang, W.; Li, M.; Wendel, H.-P.; Geis-Gerstorfer, J.; Li, P.; Wan, G.; Xu, S.; Hu, T. Biodegradable Zn-Cu-Fe Alloy as a Promising Material for Craniomaxillofacial Implants: An in Vitro Investigation into Degradation Behavior, Cytotoxicity, and Hemocompatibility. Front. Chem. 2022, 10, 860040. [Google Scholar] [CrossRef]
- Liu, A.; Qin, Y.; Dai, J.; Song, F.; Tian, Y.; Zheng, Y.; Wen, P. Fabrication and Performance of Zinc-Based Biodegradable Metals: From Conventional Processes to Laser Powder Bed Fusion. Bioact. Mater. 2024, 41, 312–335. [Google Scholar] [CrossRef]
- Chu, X.; Fu, Z.; Liu, Y.; Dai, Y.; Wang, J.; Song, J.; Dong, Z.; Yan, Y.; Yu, K. Mechanical Properties, Biodegradable Behavior and Biocompatibility of Zn-0.5Ti Alloy Membranes Produced by Powder Metallurgy for Guided Bone Regeneration. Mater. Lett. 2024, 371, 136899. [Google Scholar] [CrossRef]
- Kolawole, M.Y.; Aweda, J.O.; Abdulkareem, S.; Bello, S.A. Biodegradable Zinc Alloys and Composites for Biomedical Application: An Overview of Processing Routes and Possible Future Work. Eur. J. Mater. Sci. Eng. 2020, 5, 115–132. [Google Scholar] [CrossRef]
- Čákyová, V.; Gorejová, R.; Kupková, M.; Sopčák, T.; Strečková, M.; Fáberová, M.; Özaltin, K.; Džupon, M.; Oriňaková, R. Study of Zn-Ag Alloys Prepared via Powder Metallurgy. SSRN 2025. [Google Scholar] [CrossRef]
- Kumar, R.; Katyal, P. Effects of Alloying Elements on Performance of Biodegradable Magnesium Alloy. Mater. Today Proc. 2022, 56, 2443–2450. [Google Scholar] [CrossRef]
- Rai, A.; Rai, P.; Kumar, V.; Singh, N.K.; Singh, V.K. Effect of Sintering Temperature on the Physico-Mechanical Behavior of SiC Reinforced Zinc-Magnesium Based Composite. Met. Mater. Int. 2021, 27, 3164–3172. [Google Scholar] [CrossRef]
- Mohamad Rodzi, S.N.H.; Zuhailawati, H.; Dhindaw, B.K. Mechanical and Degradation Behaviour of Biodegradable Magnesium–Zinc/Hydroxyapatite Composite with Different Powder Mixing Techniques. J. Magnes. Alloy 2019, 7, 566–576. [Google Scholar] [CrossRef]
- TN EN ISO 6507-1; Metallic Materials—Vickers Hardness Test—Part 1: Test Method. CEN-CENELEC Management Centre: Bruxelles, Belgium, 2023.
- Dag, I.E.; Kilic, F.; Panigrahi, M.; Avar, B. Microstructure, Mechanical Properties, and Antibacterial Performance of Novel Fe-Mn-Zn Nanocrystalline Alloys Produced by Mechanical Alloying. Adv. Eng. Mater. 2025, 27, 2500049. [Google Scholar] [CrossRef]
- Dağ, İ.E.; Avar, B.; Panigrahi, M.; Gündeş, A.; Şimşek, T.; Rajendrachari, S. Evaluation of the Microstructural, Mechanical, and Corrosion Behavior of BN-, B4C-, and FeB-Added Distaloy AE Composites Produced by High-Energy Ball Milling and Hot-Pressing. Metallogr. Microstruct. Anal. 2025, 14, 210–228. [Google Scholar] [CrossRef]
- Suryanarayana, C. Mechanical Alloying and Milling. Prog. Mater. Sci. 2001, 46, 1–184. [Google Scholar] [CrossRef]
- Sumner, M.; Harison, J.; Elda, S. Pearson New International Edition. In British Library Cataloguing-in-Publication Data; British Library: London, UK, 2018; ISBN 9781118895238. [Google Scholar]
- Suryanarayana, C.; Norton, M.G. (Eds.) X-Rays and Diffraction BT. In X-Ray Diffraction: A Practical Approach; Springer US: Boston, MA, USA, 1998; pp. 3–19. ISBN 978-1-4899-0148-4. [Google Scholar]
- Liu, Z.; Qiu, D.; Wang, F.; Taylor, J.A.; Zhang, M. The Grain Refining Mechanism of Cast Zinc through Silver Inoculation. Acta Mater. 2014, 79, 315–326. [Google Scholar] [CrossRef]
- Sikora-Jasinska, M.; Mostaed, E.; Mostaed, A.; Beanland, R.; Mantovani, D.; Vedani, M. Fabrication, Mechanical Properties and in Vitro Degradation Behavior of Newly Developed ZnAg Alloys for Degradable Implant Applications. Mater. Sci. Eng. C 2017, 77, 1170–1181. [Google Scholar] [CrossRef]
- Valdez, S.; Campillo, B.; Pérez, R.; Martínez, L.; García H, A. Synthesis and Microstructural Characterization of Al–Mg Alloy–SiC Particle Composite. Mater. Lett. 2008, 62, 2623–2625. [Google Scholar] [CrossRef]
- Xie, Y.; Zhao, L.; Zhang, Z.; Wang, X.; Wang, R.; Cui, C. Fabrication and Properties of Porous Zn-Ag Alloy Scaffolds as Biodegradable Materials. Mater. Chem. Phys. 2018, 219, 433–443. [Google Scholar] [CrossRef]
- Yilmazer, H.; Basit, S.; Sen, A.; Yilmazer, Y.; Dalbayrak, B.; Arisan, E.D.; Arisan, S.; Islamgaliev, R.K.; Dikici, B. A Comprehensive Study on Microstructure, in-Vitro Biodegradability, Bacterial Sensitivity, and Cellular Interactions of Novel Ternary Zn-Cu-XAg Alloys for Urological Applications. J. Alloys Compd. 2023, 965, 171290. [Google Scholar] [CrossRef]
- Akinwekomi, A.D.; Akhtar, F. Tunability of Mechanical and Biodegradation Properties of Zinc-Based Biomaterial with Calcium Micronutrient Alloying. J. Mech. Behav. Biomed. Mater. 2023, 140, 105724. [Google Scholar] [CrossRef] [PubMed]
- Youness, R.A.; Taha, M.A. Tuning Biodegradability, Bone-Bonding Capacity, and Wear Resistance of Zinc-30% Magnesium Intermetallic Alloy for Use in Load-Bearing Bone Applications. Sci. Rep. 2024, 14, 2425. [Google Scholar] [CrossRef]
- Yan, Y.; Cao, H.; Kang, Y.; Yu, K.; Xiao, T.; Luo, J.; Deng, Y.; Fang, H.; Xiong, H.; Dai, Y. Effects of Zn Concentration and Heat Treatment on the Microstructure, Mechanical Properties and Corrosion Behavior of as-Extruded Mg-Zn Alloys Produced by Powder Metallurgy. J. Alloys Compd. 2017, 693, 1277–1289. [Google Scholar] [CrossRef]
- Jara-Chávez, G.; Amaro-Villeda, A.; Campillo-Illanes, B.; Ramírez-Argáez, M.; González-Rivera, C. Effect of Ag and Cu Content on the Properties of Zn-Ag-Cu-0.05Mg Alloys. Metals 2024, 14, 740. [Google Scholar] [CrossRef]
- Xiao, X.; Wang, B.; Liu, E.; Liu, H.; Liu, L.; Xu, W.; Ge, S.; Shao, J. Investigation of Zinc-Silver Alloys as Biodegradable Metals for Orthopedic Applications. J. Mater. Res. Technol. 2023, 26, 6287–6303. [Google Scholar] [CrossRef]
- Zhou, L.; Zhang, J.; Tian, Y.; Wang, J.; He, D. Comparison of the Relationship between Hardness and Wear Resistance of Polycrystalline Diamond and Cubic Boron Nitride. J. Am. Ceram. Soc. 2024, 107, 5412–5420. [Google Scholar] [CrossRef]
- Tong, X.; Wang, H.; Zhu, L.; Han, Y.; Wang, K.; Li, Y.; Ma, J.; Lin, J.; Wen, C.; Huang, S. A Biodegradable in Situ Zn–Mg2Ge Composite for Bone-Implant Applications. Acta Biomater. 2022, 146, 478–494. [Google Scholar] [CrossRef]
- Li, H.; Huang, J.; Zhang, P.; Zhang, Q. Investigation on Tribological Behaviors of Biodegradable Pure Zn and Zn-X (Li, Cu, Ge) Binary Alloys. J. Mater. Sci. Mater. Med. 2021, 32, 149. [Google Scholar] [CrossRef]
- Krüger, J.T.; Hoyer, K.-P.; Schaper, M. Bioresorbable AgCe and AgCeLa Alloys for Adapted Fe-Based Implants. Mater. Lett. 2022, 306, 130890. [Google Scholar] [CrossRef]
- Schinhammer, M.; Hänzi, A.C.; Löffler, J.F.; Uggowitzer, P.J. Design Strategy for Biodegradable Fe-Based Alloys for Medical Applications. Acta Biomater. 2010, 6, 1705–1713. [Google Scholar] [CrossRef] [PubMed]
- Guan, Z.; Linsley, C.S.; Pan, S.; DeBenedetto, C.; Liu, J.; Wu, B.M.; Li, X. Highly Ductile Zn-2Fe-WC Nanocomposite as Biodegradable Material. Metall. Mater. Trans. A 2020, 51, 4406–4413. [Google Scholar] [CrossRef] [PubMed]
- Gabay, N.; Ron, T.; Vago, R.; Shirizly, A.; Aghion, E. Evaluating the Prospects of Ti-Base Lattice Infiltrated with Biodegradable Zn–2%Fe Alloy as a Structural Material for Osseointegrated Implants—In Vitro Study. Materials 2021, 14, 4682. [Google Scholar] [CrossRef]
- Nová, K.; Novák, P.; Průša, F.; Kopeček, J.; Čech, J. Synthesis of Intermetallics in Fe-Al-Si System by Mechanical Alloying. Metals 2019, 9, 20. [Google Scholar] [CrossRef]
- Gaylan, Y.; Avar, B.; Panigrahi, M.; Aygün, B.; Karabulut, A. Effect of the B4C Content on Microstructure, Microhardness, Corrosion, and Neutron Shielding Properties of Al–B4C Composites. Ceram. Int. 2023, 49, 5479–5488. [Google Scholar] [CrossRef]
- Tong, X.; Dong, Y.; Han, Y.; Zhou, R.; Zhu, L.; Zhang, D.; Dai, Y.; Shen, X.; Li, Y.; Wen, C.; et al. A Biodegradable Zn-5Gd Alloy with Biomechanical Compatibility, Cytocompatibility, Antibacterial Ability, and in Vitro and in Vivo Osteogenesis for Orthopedic Applications. Acta Biomater. 2024, 177, 538–559. [Google Scholar] [CrossRef]
- TN EN ISO10993-5:2009; Part 5: Tests for In Vitro Cytotoxicity. International Organization for Standardization: Geneva, Switzerland, 2009.
- Shi, Z.-Z.; Yu, J.; Liu, X.-F.; Zhang, H.-J.; Zhang, D.-W.; Yin, Y.-X.; Wang, L.-N. Effects of Ag, Cu or Ca Addition on Microstructure and Comprehensive Properties of Biodegradable Zn-0.8Mn Alloy. Mater. Sci. Eng. C 2019, 99, 969–978. [Google Scholar] [CrossRef]
- Chen, C.; Yue, R.; Zhang, J.; Huang, H.; Niu, J.; Yuan, G. Biodegradable Zn-1.5Cu-1.5Ag Alloy with Anti-Aging Ability and Strain Hardening Behavior for Cardiovascular Stents. Mater. Sci. Eng. C 2020, 116, 111172. [Google Scholar] [CrossRef]
- Wang, X.; Liu, A.; Zhang, Z.; Hao, D.; Liang, Y.; Dai, J.; Jin, X.; Deng, H.; Zhao, Y.; Wen, P.; et al. Additively Manufactured Zn-2Mg Alloy Porous Scaffolds with Customizable Biodegradable Performance and Enhanced Osteogenic Ability. Adv. Sci. 2024, 11, 2307329. [Google Scholar] [CrossRef]

| Sample | Theoretical Density (g/cm3) | Density Before Sintering (g/cm3) | Density After Sintering (g/cm3) | Porosity Before Sintering (%) | Porosity After Sintering (%) |
|---|---|---|---|---|---|
| Zn | 7.14 | 5.89 ± 0.07 | 6.31 ± 0.02 | 17.51 ± 0.97 | 11.62 ± 0.28 |
| Zn-3Ag | 7.21 | 5.76 ± 0.04 | 6.22 ± 0.06 | 20.11 ± 0.56 | 13.73 ± 0.84 |
| Zn-3Ag-1Fe | 7.22 | 5.66 ± 0.08 | 6.14 ± 0.08 | 21.61 ± 1.12 | 14.95 ± 1.10 |
| Zn-3Ag-3Fe | 7.23 | 5.75 ± 0.03 | 6.18 ± 0.01 | 20.47 ± 0.42 | 14.52 ± 0.14 |
| Zn-3Ag-5Fe | 7.25 | 5.62 ± 0.05 | 6.12 ± 0.04 | 22.26 ± 0.47 | 15.35 ± 0.32 |
| Sample | OCP (mV) | Ecorr (mV) | Icorr (µA/cm2) | Corrosion Rate (mm/Year) |
|---|---|---|---|---|
| Zn | −986.7 | −1119.2 | 29.44 | 0.51 |
| Zn3Ag | −984.0 | −1086.1 | 33.12 | 0.56 |
| Zn3Ag1Fe | −965.4 | −1079.6 | 51.61 | 0.88 |
| Zn3Ag3Fe | −957.5 | −959.3 | 154.19 | 2.63 |
| Zn3Ag5Fe | −774.6 | −779.5 | 164.65 | 2.81 |
| Sample | Ro (Ωcm2) | Rm (Ωcm2) | Rtotal (Ωcm2) |
|---|---|---|---|
| Zn | 183.81 | 78.24 | 262.05 |
| Zn3Ag | 41.47 | 188.74 | 230.21 |
| Zn3Ag1Fe | 16.07 | 183.76 | 199.83 |
| Zn3Ag3Fe | 41.12 | 117.21 | 158.33 |
| Zn3Ag5Fe | 8.66 | 101.84 | 110.5 |
Disclaimer/Publisher’s Note: The statements, opinions and data contained in all publications are solely those of the individual author(s) and contributor(s) and not of MDPI and/or the editor(s). MDPI and/or the editor(s) disclaim responsibility for any injury to people or property resulting from any ideas, methods, instructions or products referred to in the content. |
© 2025 by the authors. Licensee MDPI, Basel, Switzerland. This article is an open access article distributed under the terms and conditions of the Creative Commons Attribution (CC BY) license (https://creativecommons.org/licenses/by/4.0/).
Share and Cite
Dag, I.E.; Erdal, E.; Mhadhbi, M.; Avar, B. Effect of Iron on the Microstructure, Mechanical Properties, Corrosion Behavior, and Biocompatibility of Mechanically Alloyed Zn-3Ag Biodegradable Alloys. J. Funct. Biomater. 2025, 16, 435. https://doi.org/10.3390/jfb16120435
Dag IE, Erdal E, Mhadhbi M, Avar B. Effect of Iron on the Microstructure, Mechanical Properties, Corrosion Behavior, and Biocompatibility of Mechanically Alloyed Zn-3Ag Biodegradable Alloys. Journal of Functional Biomaterials. 2025; 16(12):435. https://doi.org/10.3390/jfb16120435
Chicago/Turabian StyleDag, Ilker Emin, Ebru Erdal, Mohsen Mhadhbi, and Baris Avar. 2025. "Effect of Iron on the Microstructure, Mechanical Properties, Corrosion Behavior, and Biocompatibility of Mechanically Alloyed Zn-3Ag Biodegradable Alloys" Journal of Functional Biomaterials 16, no. 12: 435. https://doi.org/10.3390/jfb16120435
APA StyleDag, I. E., Erdal, E., Mhadhbi, M., & Avar, B. (2025). Effect of Iron on the Microstructure, Mechanical Properties, Corrosion Behavior, and Biocompatibility of Mechanically Alloyed Zn-3Ag Biodegradable Alloys. Journal of Functional Biomaterials, 16(12), 435. https://doi.org/10.3390/jfb16120435

